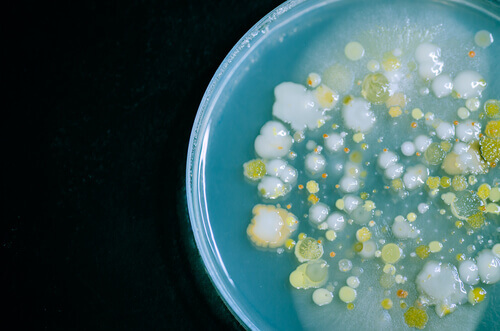
kolonie bakterii

Choroby skórne u psów - jak je leczyć?


Napisane i zweryfikowane przez biologa Ana Díaz Maqueda
Choroby skórne u psów są znane jako ropne zapalenie skóry i mają pochodzenie bakteryjne. Choroby skórne u psów są częstsze niż moglibyśmy przypuszczać. Jeśli nie zostaną odpowiednio wyleczone mogą przerzucić się na inne narządy. Mogą nawet prowadzić do sepsy i śmierci psa.
Te infekcje są znane jako ropne zapalenie skóry i mogą mieć różne stopnie: powierzchniowe i głębokie. Pierwszy dotyczą wyłącznie tkanki naskórka – najbardziej powierzchownej warstwy skóry – a drugi uszkadza skórę właściwą i tkanki głębsze.
Najczęstszymi objawami w powierzchownych ropnych chorobach skórach są zaczerwienienie, krosty, łuszczenie się, strupki, łysienie i swędzenie. W przypadku głębokich chorób skórnych stwierdzone zmiany naskórkowe są bardziej bolesne i rzadko pojawia się swędzenie.
Są to wrzody, krwotoczne guzki, z których w większości przypadków wydziela się krew wraz z innymi płynami zakaźnymi.
Musimy być bardzo ostrożni w przypadku infekcji skóry psów. W większości przypadków są odzwierzęce i mogą być przenoszone na ludzi. Mikroorganizmami najczęściej występującymi w tych zakażeniach są Staphylococcus intermedius i Staphylococcus aureus.
Specjalne szampony
Leczenie piodermii musi być zarówno miejscowe, jak i ogólnoustrojowe. Do leczenia miejscowego najlepszą opcją są szampony, ponieważ dobrze wnikają w skórę. Najczęściej używa się tych, które mają jeden z tych składników:
- Nadtlenek benzoilu
- Mleczan etylu
- Chlorheksydyna
- Jodopowidon
Zastosowanie tych szamponów pomaga oczyścić zranioną skórę, co sprzyja gojeniu, zmniejsza ból i swędzenie. Powinniśmy je stosować co najmniej dwa razy w tygodniu, chociaż lekarz weterynarii może zalecić inaczej.
Fluorochinolony w leczeniu infekcji skóry u psów
Fluorochinolony to grupa antybiotyków o szerokim spektrum działania (zwalczają wiele bakterii). Skuteczność terapeutyczną tych leków wykazano w 85,4% przypadków. Jednak 4,9% psom nie pomogły.

Główne problemy z fluorochinolonami polegają na tym, że mogą powodować oporność bakteryjną. Po leczeniu grupa bakterii, które początkowo nie stanowiły problemu tworzy odporność na antybiotyk i rośnie. Powoduje to pojawienie się nowych nieuleczalnych infekcji.
Choroby skórne – ryfampicyny
Ryfampicyny to kolejna grupa antybiotyków, zwykle stosowanych w walce z przewlekłym głębokim ropnym zapaleniem skóry.

Podobnie jak fluorochinolony, mogą powodować oporność bakteryjną, ponieważ są to również antybiotyki o szerokim spektrum działania.
Choroby skórne psów – co zrobić?
Leczenie infekcji skóry jest na ogół empiryczne. W zależności od ciężkości przypadku zaczyna się od stosowania środków antyseptycznych i miejscowych antybiotyków (mupirocyna lub kwas fusydowy).
Stosowanie ogólnoustrojowych antybiotyków jest zastrzeżone dla cięższych przypadków.
Jednak masowe stosowanie tych leków, bez wcześniejszych badań mikrobiologicznych, doprowadziło do wzrostu oporności bakteryjnej, oprócz niewłaściwego stosowania niektórych antybiotyków, takich jak penicylina lub metycylina, które okazały się bezużyteczne w leczeniu tych gronkowców.
Jeśli podejrzewasz, że Twoje zwierzę może mieć infekcję skóry jak najszybciej udaj się do weterynarza. Czasami niektóre zmiany skórne mogą być przyczyną innych rodzajów patologii, takich jak alergie, świerzb lub leiszmanioza.
Jeśli lekarz weterynarii przepisuje antybiotyki, konieczne jest uważne przestrzeganie zaleceń dotyczących dawkowania, aby uzyskać pozytywne wyniki i uniknąć możliwej oporności.
Choroby skórne u psów są znane jako ropne zapalenie skóry i mają pochodzenie bakteryjne. Choroby skórne u psów są częstsze niż moglibyśmy przypuszczać. Jeśli nie zostaną odpowiednio wyleczone mogą przerzucić się na inne narządy. Mogą nawet prowadzić do sepsy i śmierci psa.
Te infekcje są znane jako ropne zapalenie skóry i mogą mieć różne stopnie: powierzchniowe i głębokie. Pierwszy dotyczą wyłącznie tkanki naskórka – najbardziej powierzchownej warstwy skóry – a drugi uszkadza skórę właściwą i tkanki głębsze.
Najczęstszymi objawami w powierzchownych ropnych chorobach skórach są zaczerwienienie, krosty, łuszczenie się, strupki, łysienie i swędzenie. W przypadku głębokich chorób skórnych stwierdzone zmiany naskórkowe są bardziej bolesne i rzadko pojawia się swędzenie.
Są to wrzody, krwotoczne guzki, z których w większości przypadków wydziela się krew wraz z innymi płynami zakaźnymi.
Musimy być bardzo ostrożni w przypadku infekcji skóry psów. W większości przypadków są odzwierzęce i mogą być przenoszone na ludzi. Mikroorganizmami najczęściej występującymi w tych zakażeniach są Staphylococcus intermedius i Staphylococcus aureus.
Specjalne szampony
Leczenie piodermii musi być zarówno miejscowe, jak i ogólnoustrojowe. Do leczenia miejscowego najlepszą opcją są szampony, ponieważ dobrze wnikają w skórę. Najczęściej używa się tych, które mają jeden z tych składników:
- Nadtlenek benzoilu
- Mleczan etylu
- Chlorheksydyna
- Jodopowidon
Zastosowanie tych szamponów pomaga oczyścić zranioną skórę, co sprzyja gojeniu, zmniejsza ból i swędzenie. Powinniśmy je stosować co najmniej dwa razy w tygodniu, chociaż lekarz weterynarii może zalecić inaczej.
Fluorochinolony w leczeniu infekcji skóry u psów
Fluorochinolony to grupa antybiotyków o szerokim spektrum działania (zwalczają wiele bakterii). Skuteczność terapeutyczną tych leków wykazano w 85,4% przypadków. Jednak 4,9% psom nie pomogły.

Główne problemy z fluorochinolonami polegają na tym, że mogą powodować oporność bakteryjną. Po leczeniu grupa bakterii, które początkowo nie stanowiły problemu tworzy odporność na antybiotyk i rośnie. Powoduje to pojawienie się nowych nieuleczalnych infekcji.
Choroby skórne – ryfampicyny
Ryfampicyny to kolejna grupa antybiotyków, zwykle stosowanych w walce z przewlekłym głębokim ropnym zapaleniem skóry.
Podobnie jak fluorochinolony, mogą powodować oporność bakteryjną, ponieważ są to również antybiotyki o szerokim spektrum działania.
Choroby skórne psów – co zrobić?
Leczenie infekcji skóry jest na ogół empiryczne. W zależności od ciężkości przypadku zaczyna się od stosowania środków antyseptycznych i miejscowych antybiotyków (mupirocyna lub kwas fusydowy).
Stosowanie ogólnoustrojowych antybiotyków jest zastrzeżone dla cięższych przypadków.
Jednak masowe stosowanie tych leków, bez wcześniejszych badań mikrobiologicznych, doprowadziło do wzrostu oporności bakteryjnej, oprócz niewłaściwego stosowania niektórych antybiotyków, takich jak penicylina lub metycylina, które okazały się bezużyteczne w leczeniu tych gronkowców.
Jeśli podejrzewasz, że Twoje zwierzę może mieć infekcję skóry jak najszybciej udaj się do weterynarza. Czasami niektóre zmiany skórne mogą być przyczyną innych rodzajów patologii, takich jak alergie, świerzb lub leiszmanioza.
Jeśli lekarz weterynarii przepisuje antybiotyki, konieczne jest uważne przestrzeganie zaleceń dotyczących dawkowania, aby uzyskać pozytywne wyniki i uniknąć możliwej oporności.
Wszystkie cytowane źródła zostały gruntownie przeanalizowane przez nasz zespół w celu zapewnienia ich jakości, wiarygodności, aktualności i ważności. Bibliografia tego artykułu została uznana za wiarygodną i dokładną pod względem naukowym lub akademickim.
- Beco, L., Guaguère, E., Lorente Méndez, C., Noli, C., Nuttall, T., & Vroom, M. (2013). Guía para el uso de antibióticos sistémicos en el tratamiento de infecciones cutáneas. Parte I: diagnóstico en base a la presentación clínica, citología y cultivo. Veterinary Record, 2013, 72-78.
- Castellanos, L., Rodríguez, M., & Santos, A. (2011). Aislamiento e identificación bioquímica de microorganismos bacterianos a partir de infecciones de piel en caninos. Revista de Medicina Veterinaria, 1(22), 21-30.
- Carlotti, D. N., & Atance, A. (1997). El empleo de la rifampicina en el tratamiento de las piodermas profundas crónicas del perro: revisión bibliográfica y presentación de trece casos clínicos. Clínica veterinaria de pequeños animales, 17(4), 0211-226.
- Denamiel, G., Puigdevall, T., Más, J., Albarellos, G., & Gentilini, E. (2009). Prevalencia y perfil de resistencia a betalactámicos en estafilococos de perros y gatos. InVet, 11(2), 117-122.
- González, J. L., Bravo, V., Peña, A., & Beral, M. (2006). Dermatología. Eficacia terapéutica del orifloxacino (Orbax) en el tratamiento de la pioderma canina: un estudio cínico abierto. Clínica veterinaria de pequeños animales, 26(1), 0009-12.
- Herrera-Arana, V., González, J., & Iglesia-Quilca, D. (2006). Actualización en el manejo de antibióticos en las infecciones superficiales de piel y partes blandas. Acta medica peruana, 23(1), 32-34.
- RÍOS AM, B. M., Ortiz, G., Ayllón, T., Smit, L., Rodríguez, D. M., & Sánchez, D. A. (2015). Staphylococcus multirresistentes a los antibióticos y su importancia en medicina veterinaria. Clínica Veterinaria de Pequeños Animales AVEPA, 35(3), 149-161.
Ten tekst jest oferowany wyłącznie w celach informacyjnych i nie zastępuje konsultacji z profesjonalistą. W przypadku wątpliwości skonsultuj się ze swoim specjalistą.







